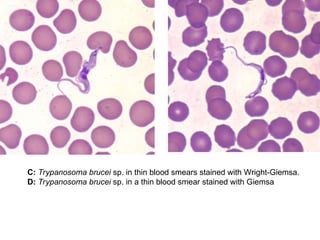
C: Trypanosoma brucei sp. in thin blood smears stained with Wright-Giemsa.
D: Trypanosoma brucei sp. in a thin blood smear stained with Giemsa

This document outlines the learning objectives and key features of the genus Trypanosoma, focusing on African sleeping sickness caused by Trypanosoma brucei gambiense and T. brucei rhodesiense, transmitted by tsetse flies. It includes information on epidemiology, morphology, transmission, life cycle, laboratory diagnosis, and clinical aspects of the disease. Additionally, it compares West African and East African trypanosomiasis, detailing diagnostic methods and the significance of laboratory findings.